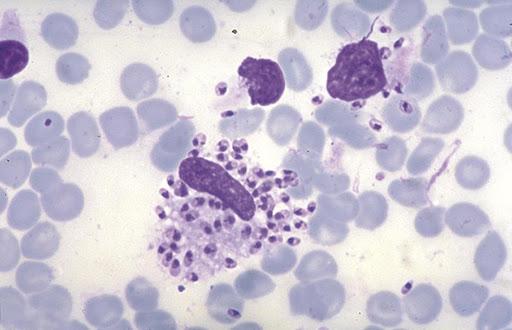
un corps de Leishman vu au microcospe

Sous les tropiques existent de nombreuses maladies dues à des parasites, dont le nom est connu du grand public comme le paludisme, la fièvre jaune ou la maladie du sommeil. Voici l’histoire passionnante de la découverte du parasite et de l’insecte responsables d’une maladie indienne moins connue, le Kala Azar.
Rédigé en collaboration avec Catherine Simonnet
Le Kala Azar, est une maladie parasitaire décrite en Inde sous de multiples noms comme la fièvre de Dum Dum, la fièvre d’Assam ou de Burdwan. Le nom Kala Azar qui vient du hindi, Kala (noir) et Azar ( fièvre) signifie Fièvre Noire, en raison de la teinte sombre que prend parfois la peau des malades infectés ou peut-être de son pronostic sombre. De nos jours, dans le langage médical, on parle de Leishmaniose Viscérale, le Kala Azar étant la forme indienne de cette maladie.
La Leishmaniose Viscérale (LV) est une maladie de progression lente, marquée par des poussées de fièvre avec un amaigrissement majeur associée à une anémie. L’évolution est défavorable en l’absence de traitement. D’après l’OMS, c’est la maladie parasitaire qui, après le paludisme, tue le plus dans le monde. La plupart des cas observés en Asie du Sud l'étaient en Inde (Bihar, Bengale et Assam) et dans les pays limitrophes, Népal et Bangladesh.
Il existe aussi en Inde la Leishmaniose dermique post Kala Azar (LDPKA), séquelle de la Leishmaniose Viscérale. Décrite par Upendranath BRAHMACHARI en 1922, elle survient plusieurs mois ou années après une LV avec l’apparition de nodules cutanés.
La maladie est identifiée assez rapidement
Initialement confondu avec le paludisme, le Kala Azar a été décrit pour la première fois à Jessore dans la province du Bengale administrée par l’East India Company. D’après les récits, à la fin de l’année 1824, les habitants de Jessore sont décimés : “Leur peau prend un teint terreux, ils maigrissent, s’anémient, de grosses veines bleuâtres courent sur leur abdomen distendu et finalement une dysenterie ou une pneumonie foudroyante les emportent”.

L’épidémie progresse ensuite dans toute la plaine du Gange, elle atteint le Bengale occidental, Dacca (la capitale du Bangladesh actuel), puis Jageer. L’épidémie est telle qu’en quatre ans la population de Jageer disparaît, au point que la ville ne figure plus sur aucune carte.
De retour en Inde comme médecin militaire, le Dr Gopaul Chunder ROY premier indien diplômé de l’Université de Glasgow, publie en 1876 La fièvre de Burdwan : causes, symptômes et traitement. Il y décrit la progression en tâche d’huile de l’épidémie et sa saisonnalité avec une accalmie trompeuse en hiver, précédant sa réapparition violente avec la mousson.

Puis, sous l’impulsion des colonisateurs anglais, le développement des voies navigables sur le Gange et le Brahmapoutre favorise la dissémination de la maladie dans l’Assam récemment conquis aux Birmans. Avec une remarquable perspicacité, les Assamais appellent ce nouveau fléau, Sorkari Bunari, littéralement la maladie du gouvernement.
Finalement, la maladie dévaste le Bengale, le Bihar et l’Assam. On estime qu’en 25 ans, un quart de la population disparait, puis l’épidémie perd de sa vigueur et la population retrouve une vie normale. Mais la nature et le mode de transmission de la maladie restent inconnus.
L’agent causal du Kala Azar est découvert en deux temps
C’est alors que les découvertes de Pasteur en France et de Koch en Allemagne font naître le concept de maladie infectieuse, inaugurant l’ère de grandes découvertes.
Alphonse Laveran découvre en 1880 le parasite responsable du paludisme, Ford et Dutton en 1901 celui responsable de la maladie du sommeil dont le vecteur, la fameuse mouche Tsé Tsé, est identifié deux ans plus tard.
Bien que les services médicaux anglais connaissent un début d’organisation dès 1764, l’Indian Medical Service (IMS) est créé en 1856. Sous l’impulsion de médecins anglais, souvent militaires, des recherches sont entreprises pour mettre en évidence l’agent causal du Kala Azar.

Après quelques fausses pistes, l’idée d’un agent causal spécifique fait son chemin et le parasite responsable est formellement identifié en deux temps.
Un soldat britannique, basé dans la banlieue de Calcutta à la garnison de Dum Dum, connu pour sa fameuse fièvre (Dum Dum fever) et son arsenal (tristement célèbre pour la manufacture de balles à expansion du même nom), supposé atteint d’une forme cachectisante de paludisme, est rapatrié en 1900 à l’hôpital militaire de Netley en Angleterre où il meurt.

William Boog LEISHMAN, ancien médecin de l’IMS, réalise à l’hôpital de Netley un examen post-mortem et un prélèvement de rate. Sous son microscope, il découvre grâce à une coloration qu’il a mise au point, de nombreux éléments sous forme de micro-corpuscules ovoïdes, qui sont alors simplement nommés “corps de Leishman”.

En 1903, à l’Hôpital Gouvernemental de Madras, Charles DONOVAN, médecin militaire de l’IMS, trouve sur la ponction de rate d’un patient atteint de Kala Azar, les mêmes corpuscules ovoïdes que ceux décrits par Leishman. Il conclut qu’il s’agit d’un nouveau parasite et qu’il est l’agent causal du Kala Azar.

Le parasite responsable du Kala Azar est identifié et le nom de LEISHMANIA DONOVANI lui est donné à partir de ceux de ses découvreurs. Mais le mode de transmission du Leishmania Donovani n’est pas encore connu.

La longue recherche sur le vecteur de la maladie
Le parasite responsable du Kala Azar, Leishamania Donovani, est découvert en 1903. Mais la manière dont il pénètre dans le corps humain va mettre 40 ans pour se dévoiler.
A cette époque, le vecteur est bien identifié pour d’autres maladies parasitaires : le rôle du moustique, l’anophèle femelle, dans la transmission du paludisme est découvert en 1898 par Ronald ROSS qui obtient le Prix Nobel de médecine en 1902.

Mais l'évolution des connaissances sur le Kala Azar est beaucoup plus lente, alors que les épidémies se succèdent : on estime qu’entre 1918 et 1923, 200 000 personnes en meurent dans l’Assam et la vallée du Brahmapoutre.
En laboratoire, sous microscope, le parasite responsable du Kala Azar apparaît sous une forme ovoïde. En 1904, sa mise en culture par L. ROGERS fait avancer les connaissances : le parasite se transforme alors en un corps fuselé avec un appendice (flagelle) antérieur. Ces deux formes représentent les deux stades de la vie du parasite.
Ces organismes flagellés (appelés promastigotes) avaient déjà été observés par des zoologistes dans le tube digestif d’insectes piqueurs, mouches et punaises.

Après plusieurs années de recherches, la possibilité d’une punaise comme vecteur du Kala Azar est abandonnée.
L’hypothèse de la responsabilité d’une mouche est reprise. Dans l’Himachal Pradesh, à Kausali, J.A. SINTON se charge de trouver le postulant. En bon militaire, il étudie les cartes et constate que celle des régions où sévit le Kala Azar se superpose parfaitement de l’Assam à Madras, à celle d’un moucheron argenté, le Phlebotomus Argentipes. Nous sommes en 1924, le vecteur probable est identifié et la chasse au phlébotome est lancée.

Le phlébotome est un moucheron minuscule (2,5 mm) aux ailes dressées en V, dont l'activité est essentiellement vespérale et nocturne. Seule la femelle se nourrit de sang : elle est hématophage. Dans la journée, ce moucheron se cache dans des recoins humides et ombragés des zones tropicales où il est très difficile à voir. Et sa petite taille lui permet de passer à travers les mailles des mousquaires.

En 1925, R. KNOWLES avec l’équipe de l’Ecole de Médecine Tropicale de Calcutta, met en évidence la présence du parasite dans l'intestin de phlébotomes femelles qui avaient été mis en contact avec des malades atteints de Kala Azar.
Il reste alors à prouver qu’un phlébotome infecté peut contaminer un humain et lui transmettre le Kala Azar.
L’erreur a été de croire très longtemps que le phlébotome femelle se comportait comme l’anophèle femelle, le vecteur du paludisme. Dans ces deux espèces, les mâles sont végétariens et se nourrissent de sucs de plantes et de fruits. L’anophèle femelle qui transmet le paludisme, ne se nourrit que de sang.
En 1939 au Bihar, R.O. SMITH découvre dans son laboratoire, à force de patience, que pour être infestantes, c'est-à-dire transmettre le parasite, les femelles phlébotomes qui se nourrissent de sang, doivent aussi faire des repas végétariens.
Forts de cette découverte, H.E. SHORTT et un chercheur indien C.S. SWAMINATH réunissent en 1940 dans l’Assam, six volontaires indiens en les mettant en présence de phlébotomes infestants. Et ils prouvent la transmission du parasite : 3 volontaires contractent le Kala Azar.
En 1940, soit presque 40 ans après la découverte du Leishmania-donovani, le mode de transmission du parasite est enfin connu : le Kala Azar est transmis par la piqûre d’un moucheron, un phlébotome femelle infecté à partir d’un autre humain porteur du parasite.
Et en Inde, l’humain est le réservoir unique de Leishmania Donovani responsable du Kala-Azar, la forme indienne de la Leishmaniose viscérale.
Traitements curatifs, préventifs et l’avenir
Toute maladie mobilise des chercheurs pour trouver une thérapeutique. Le premier traitement efficace et non toxique contre le Kala Azar nommé Uréa-Stibamine, est synthétisé en 1922 par Upendranath BRAHMACHARI, qui est nominé pour le Prix Nobel de Médecine.

Ce médicament diminue de façon spectaculaire la mortalité qui en dix ans, de 1925 à 1935, passe dans l’Assam de 6 300 à 750 décès.

En 1939, le chimiste suisse Paul MULLER découvre le premier insecticide connu par ses initiales, le DDT, largement utilisé dans la lutte contre le paludisme. Il obtient en 1948 le Prix Nobel de Médecine comme “bienfaiteur de l’humanité”.
En 1952, l’Inde devenue indépendante lance avec l’aide de l’OMS son programme d’éradication du paludisme, qui donne des résultats inattendus sur le Kala Azar, le phlébotome se révélant plus sensible que l’anophèle au DDT : au milieu des années 50, il n’y a pratiquement plus de malades et en 1965 le Kala Azar est oublié.
Mais la toxicité du DDT et la découverte de la Chloroquine, médicament bon marché et efficace, conduisent en 1970 à l’arrêt du programme d'éradication du paludisme et ... le Kala Azar réapparaît au Bihar. L’épidémie se répand, atteignant en 1975 le Bengale occidental, en 1977 la majeure partie du Bihar, en 1980 l’Uttar Pradesh, le Bangladesh et enfin le Teraï au Népal.
Des programmes nationaux de lutte contre le Kala Azar sont alors mis en place, mais la maladie persiste de manière endémique, malgré la découverte de nouveaux médicaments très efficaces.
En 2005, l’Inde, le Népal et le Bangladesh signent un protocole d’accord de lutte contre le Kala Azar dont les résultats sont spectaculaires : le nombre de cas annuels signalés passe de 32 803 en 2005 à 3 128 cas en 2019, faisant envisager d’atteindre le seuil d’élimination du Kala Azar en 2020, objectif repoussé en 2023 à cause du Covid-19.

Sur le même sujet